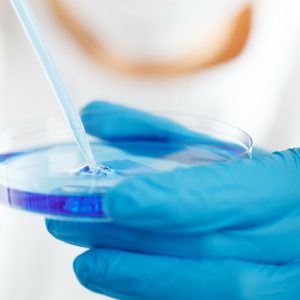

New Study Reveals: Hidden Risks of Pesticides in Popular Fruits and How to Avoid Them
Dr. Don Colbert – As a healthcare professional committed to promoting holistic health and well-being, I find it increasingly important to discuss the implications of pesticide exposure from non-organic produce.…
Signs You Are Too Hard on Yourself
Dr. Caroline Leaf – In this podcast (episode #588) and blog, I talk about why being hard on yourself can cause unnecessary stress, and how to manage your self-expectations. This is…
Fungus Breaks Down Ocean Plastic
Royal Netherlands Institute for Sea Research via EurekAlert! – A fungus living in the sea can break down the plastic polyethylene, provided it has first been exposed to UV radiation from…
An Antidiabetic Helps the Immune System Recognize Reservoirs of HIV
Universite de Montreal via Newswise – Metformin, a drug used to treat type 2 diabetes, could help deplete the viral reservoir and eliminate it entirely in people living with HIV who…
Blood thinners: A Leading Cause of Death in Emergency Rooms
Lori Alton via NaturalHealth365 – Anticoagulants, also known as blood thinners, have been around for many decades. These medications have been used for a variety of conditions and situations where…
Johnson & Johnson Pays $1.7b for Innovative Israeli Heart Failure Treatment
Zachy Hennessey via Israel21c – Big pharma giant shells out $1.7 billion for Israeli company V-Wave, and expects to earn enough to purchase a gumball — in the short term, at least.…
CDC Study: Significantly Higher Lyme Disease Rates Among Older Adults Than Previously Reported
Dr. Sanchari Sinha Dutta, Ph.D. via News-Medical – The U.S. Centers for Disease Control and Prevention (CDC), in association with the University of Iowa, USA, has conducted an epidemiological study to…
The Wrong Kind of Food Linked to Increased Depression Risk
Patrick Tims via NaturalHealth365 – Technology and social isolation are frequently cited as major factors in the rising depression epidemic both in the United States and around the world. While…
Amino Acids & Mental Health
Dr. Caroline Leaf – In this podcast (episode #589) and blog, I talk to Angelo Keely, co-founder and CEO of Kion Aminos, about the role protein plays in our mental and…
Government Report Links Fluoride Intake to Lowered IQ in Children
Ethan Huff via Natural News – The United States government has once again found that consuming fluoride is really dangerous, especially for children. A new report from the National Toxicology…
Fortified Eggs Did Not Raise Cholesterol in Modest-Sized Cardiology Study
Duke Health – Further study needed to investigate secondary findings. DURHAM, NC – There are often conflicting headlines about whether certain foods are good or bad for you, and the…
Carpal Tunnel Syndrome May Indicate a High Risk of Developing Cardiac Amyloidosis
University of Alabama at Birmingham via EurekAlert! – Presence of carpal tunnel syndrome may indicate a high risk of developing cardiac amyloidosis, according to study from All of Us Research Program…
Seasonal Weight Gain in the Fall
Michael Greger M.D. FACLM via Nutrition Facts – SAD doesn’t just stand for the standard American diet. There’s a condition known as seasonal affective disorder that is characterized by increased…
Healing Childhood Trauma
Dr. Caroline Leaf – In this podcast (episode #590) and blog, I talk about how adverse childhood experiences can make us focus on the negative, and how we can manage this…